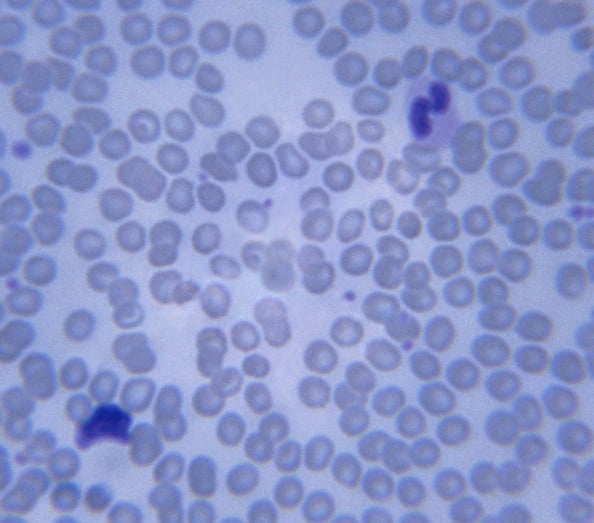

di Alessandra Tesser AIRIcerca
Editor: Lorenzo Galluzzi
Revisori Esperti: Antonio Simone Laganà, Lara Campana, Elena Tassi
Revisori Naive: Federico Forneris, Barbara Sanavio, Carla Regina
Al contrario di altre popolazioni linfocitarie, i linfociti regolatori svolgono una funzione immunosuppressiva, ossia inibiscono l’attivazione delle risposte immunitarie. Questo è particolarmente importante affinché il sistema immunitario di un organismo non si attivi contro l’organismo stesso, o contro stimoli innocui. Molti tumori però sfruttano l’attività dei linfociti regolatori per passare inosservati dal sistema immunitario e svilupparsi quasi indisturbati. Strategie per la manipolazione dei linfociti regolatori a scopo terapeutico potrebbero essere utili per il trattamento non soltanto di malattie autoimmuni ed allergiche, ma anche di diversi tipi di cancro.
Non tutti sanno che il sistema immunitario svolge diverse funzioni oltre a difenderci dalle infezioni. Ad esempio, ci permette di eliminare potenziali fonti di pericolo per l’organismo che appartengono all’organismo stesso, come cellule allo sbando che potrebbero formare tumori. Per come è costituito, però, il sistema immunitario deve anche essere in grado di tollerare i cibi di cui ci nutriamo ed i batteri che vivono in simbiosi con il nostro organismo (ad esempio la flora intestinale). Quando questo non accade, si scatenano reazioni (definite autoimmuni) anche molto violente, che possono causare danni anche molto gravi a tessuti ed organi. L’insieme di meccanismi che permettono al sistema immunitario di non reagire a stimoli di quest’ultimo tipo va sotto il nome di tolleranza immunitaria.
L’importanza del sistema immunitario come linea di difesa contro le infezioni emerge dall’osservazione che alcune malattie genetiche per cui alcuni settori del sistema immunitario non funzionano aumentano la suscettibilità dei pazienti a gravi infezioni. Queste condizioni, dette immunodeficienze primitive, vennero descritte in primo luogo nella seconda metà del secolo scorso. La scoperta delle immunodeficienze primitive permise agli scienziati di precisare il ruolo di diversi componenti del sistema immunitario partendo dall’analisi delle conseguenze della loro mancanza. In questo contesto, si capì che alcune cellule del sistema immunitario, chiamate linfociti, sono nell’insieme in grado di riconoscere virtualmente qualsiasi entità esterna all’organismo per mezzo di “sensori” che si trovano alla loro superficie. In pratica, ogni linfocita, durante il proprio sviluppo, costruisce un sensore diverso da tutti gli altri, per mezzo di meccanismi che modificano in maniera casuale (almeno in parte) una piccola porzione del suo DNA. Dato che il nostro corpo contiene un numero enorme di linfociti, ognuno dei quali esprime un sensore diverso, ce ne sarà sempre qualcuno in grado di legarsi ad una struttura molecolare (chiamata antigene) caratteristica di entità estranee, come batteri, virus e altri patogeni, che in questo modo potranno essere identificati ed eliminati.
Per molto tempo però un punto fondamentale restava oscuro: come mai questi sensori generati in modo casuale non riconoscono componenti dell’organismo stesso, dei cibi di cui ci nutriamo o delle sostanze innocue a cui siamo esposti tutti i giorni? Gli scienziati ipotizzarono quindi l’esistenza della tolleranza immunitaria. Ora è chiaro che ci sono almeno due tipi di tolleranza immunitaria, la tolleranza centrale, che provvede ad eliminare i linfociti potenzialmente pericolosi prima che questi entrino nella circolazione, e la tolleranza periferica, che tiene sotto controllo linfociti che sono già entrati in circolo (Figura 2). Un particolar gruppo di linfociti, ora conosciuti come linfociti regolatori, media (in parte) la tolleranza periferica. Nel 1995, il gruppo di Shimon Sakaguchi produsse la prima prova sperimentale a sostegno dell’esistenza dei linfociti regolatori. Tuttavia, a quell’epoca non erano note malattie genetiche che risultassero in difetti specifici dei linfociti regolatori. La teoria che un difetto di questa popolazione linfocitaria potesse coincidere con una perdita di tolleranza periferica e promuovere l’attivazione del sistema immunitario contro l’organismo restava soltanto un’ipotesi non confermata.
Grazie ai progressi tecnologici fatti in quel periodo, però, l’anello mancante venne trovato ben presto. Si scoprì infatti che la causa di una sindrome che colpisce bambini maschi nei primi anni di vita con un’impressionante sequenza di reazioni autoimmunitarie è un difetto del gene FOXP3. Questo gene è indispensabile per la formazione e il funzionamento dei linfociti regolatori. L'identificazione di una malattia associata a reazioni autoimmuni ed allergiche in pazienti con un difetto dei linfociti regolatori forniva una prova convincente del ruolo di queste cellule nel mantenimento della tolleranza immunitaria.
La conoscenza dei linfociti regolatori aprì immediatamente nuove prospettive. Sarebbe stato possibile, ad esempio, selezionare i linfociti regolatori, “allevarli” in laboratorio ed usarli come un farmaco per curare malattie con una componente autoimmune, come il diabete, la tiroidite, l’artrite reumatoide e tante altre?
La scoperta di FOXP3 sembrava aprire la strada allo sviluppo di un nuovo tipo di terapia cellulare, fornendo al tempo stesso uno strumento per l’analisi della tolleranza immunitaria in diverse malattie. Purtroppo, si scoprì ben presto che i linfociti regolatori possono avere ruoli meno desiderabili, come quelli di bloccare l’attività del sistema immunitario contro i tumori. E’ oramai noto che i tumori secernono molecole capaci di attirare i linfociti regolatori, e che l’abbondanza di queste cellule all’interno delle lesioni tumorali spesso è un indicatore prognostico negativo per i pazienti. Dal 2003 ad oggi sono stati pubblicati centinaia di lavori scientifici che dimostrano la possibilità di coltivare i linfociti regolatori in laboratorio e di infonderli in animali per prevenire l’insorgenza di malattie autoimmuni sperimentali. Inoltre, c’è tutta una linea di ricerca volta ad inibire i linfociti regolatori ed i meccanismi attraverso i quali queste cellule bloccano la risposta immunitaria contro i tumori. Non più tardi del 2011, il primo farmaco antitumorale che funziona in parte secondo questo principio, chiamato Ipilimumab, è stato approvato da vari paesi per l’uso in pazienti affetti da melanoma. Ovviamente, c’è il rischio che terapie mirate a bloccare i linfociti regolatori possano favorire lo sviluppo di malattie autoimmuni. In genere però questi fenomeni autoimmuni sono limitati e possono essere facilmente controllati con altri farmaci.
L’entusiasmo associato a queste scoperte ha attirato intorno ai linfociti regolatori l’attenzione di molti gruppi di ricerca e quella di svariati congressi scientifici e riviste. La manipolazione dei linfociti regolatori a scopi terapeutici presenta di fatto grande interesse in diversi campi della medicina. Inoltre, la conoscenza di queste cellule può essere di utilità diagnostica e prognostica. Come accennato prima, misurare la quantità di linfociti regolatori relativamente a quella di altri linfociti potrebbe permettere di seguire meglio l'evoluzione di varie malattie, fra cui svariati tipi di tumore, e di ottimizzare le scelte terapeutiche.
Molte questioni intorno ai linfociti regolatori rimangono tutt’oggi irrisolte. Ad esempio, sono stati sviluppati trattamenti in grado di stimolare i linfociti regolatori negli animali da laboratorio, ma la loro applicazione all’uomo non avuto altrettanto successo. Nuovi approcci per sfruttare le potenzialità dei linfociti regolatori dovranno tener conto dell’esistenza di altri linfociti che sono coinvolti nella tolleranza periferica e dei diversi fattori che nell’organismo condizionano la sopravvivenza, la proliferazione e la funzionalità di queste cellule. Infatti, in alcuni casi, i linfociti regolatori infusi nell’animale perdono la loro funzione naturale. Questo accade ancora più facilmente in presenza di condizioni infiammatorie, che purtroppo sono proprio le condizioni in cui si intenderebbe sfruttare il potenziale terapeutico di queste cellule.
A dieci anni dalla caratterizzazione dei linfociti regolatori sono emersi numerosi ostacoli che rallentano l’applicazione terapeutica di queste cellule. La scoperta dei linfociti regolatori ha permesso di comprendere meglio come alterazioni della tolleranza immunitaria possano contribuire all’insorgenza di condizioni autoimmuni, allergiche e tumorali. La strada delle terapie cellulari a base di linfociti regolatori però è ancora lunga ed ulteriori conoscenze sulla biologia di queste cellule sono necessarie in vista di una loro applicazione terapeutica.
L'AUTRICE - Alessandra Tesser
Nata nel 1988 a Pordenone, si è laureata in Biotecnologie Mediche nel 2012 presso l’Università degli Studi di Trieste, frequentando i Laboratori di Immunopatologia dell’I.R.C.C.S. Materno Infantile Burlo Garofolo (Ts), e concentrando il suo lavoro di tesi sui Linfociti T Regolatori. Attualmente è iscritta alla scuola di dottorato in Scienze della Riproduzione e dello Sviluppo, svolgendo la sua attività di ricerca sempre presso il Burlo Garofolo, ed occupandosi della costruzione di un profilo funzionale di pazienti con Lupus Eritematoso Sistemico e successiva correlazione con i meccanismi coinvolti in diverse forme monogeniche della malattia.